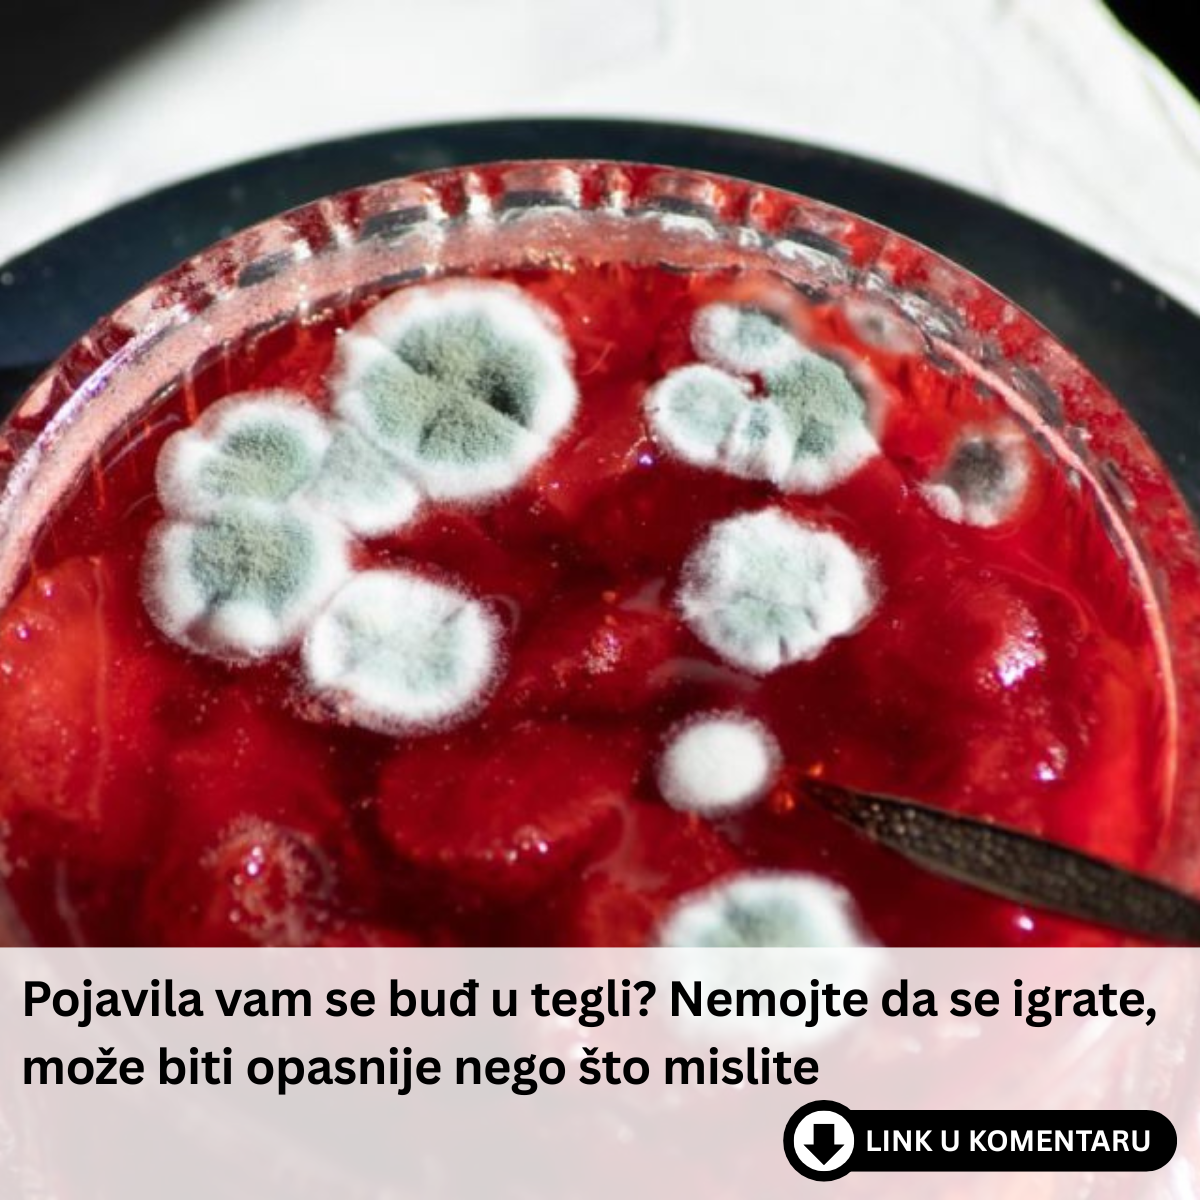

Da li Vam se ikada desilo da kada se pojavi buđ u tegli džema, Vi samo uklonite površinski dio i nastavite jesti? Ukoliko jeste, u nastavku ovog teksta otkrijte koliko je opasna ta navika i zašto bi trebalo da je ne radite…
Zima je vreme kada mnogi uživaju u pripremi domaće zimnice, a džemovi, marmelade i drugi slatki namazi često postaju nezaobilazni deo jelovnika. Međutim, tokom čuvanja domaćih džemova, jedan od najčešćih problema na koji možete naići je pojava buđi. Na prvi pogled, buđ koja se pojavljuje na površini džema može izgledati kao nešto što se lako može ukloniti, ali stručnjaci upozoravaju da to može biti mnogo opasnije nego što se čini. Zbog toga, važno je razumeti ozbiljnost ovog problema i naučiti kako pravilno reagovati kako bi se sačuvalo zdravlje i dugoročna upotreba staklenki.
- Plesan koja se pojavljuje na površini džema nije samo estetski problem. Iako mnogi često pomisle da je dovoljno odstraniti samo vidljivi sloj buđi i nastaviti koristiti ostatak džema, to je izuzetno opasno. Prehrambeno-biotehnološki fakultet upozorava da se ispod sloja buđi krije dalja mreža korenastih niti, poznatih kao micelij.

Ove niti prodire kroz čitav sadržaj tegle, što znači da je sav džem već kontaminiran, i to ne samo u delu koji je vidljiv. Pored toga, određene vrste plesni mogu stvoriti mikotoksine – otrovne supstance koje nisu vidljive, ne mogu se osetiti ili pomirisati, ali koje se nalaze u celokupnom džemu. Blic izveštava da mikotoksini mogu izazvati ozbiljne zdravstvene probleme, uključujući probavne smetnje, ali i dugoročne posledice poput oštećenja jetre i bubrega, pa čak i povećanog rizika od karcinoma. Konzumacija ovih otrovnih supstanci je stoga mnogo opasnija nego što mnogi misle.
- Jedini siguran način da se osigurate da ne rizikujete zdravlje je da se ceo sadržaj tegle baci. Iako je žao baciti domaći džem, stručnjaci napominju da je to najbezbedniji postupak. Foodie Score navodi da je rizik od mikotoksina jednostavno prevelik da bi se ignorisao. Međutim, to ne znači da treba da bacite i staklenku. Staklene tegle i poklopci mogu se višekratno koristiti, ali samo ako se temeljno operu.
Preporučuje se da tegle i poklopce operete vrućom vodom uz deterdžent, a potom ih sterilizujete kako biste uništili sve preostale spore plesni i bakterije. Na taj način možete biti sigurni da su spremni za sledeću turu pripreme zimnice. Kurir dodaje da je pravilno sterilizovanje ključ za zdravlje i sigurnost pri ponovnoj upotrebi staklenki.

Prevention, odnosno prevencija, svakako predstavlja najbolji način da se izbegnu problemi sa plesnima u džemovima. Ako želite da izbegnete da se buđ pojavi u vašim teglicama, stručnjaci predlažu nekoliko ključnih koraka. Prvi od tih koraka je besprekorno sterilizovanje staklenki i poklopaca pre nego što ih napunite džemom. Najpouzdanija metoda za sterilizaciju je kuvanje u ključaloj vodi najmanje 10 minuta. Ovaj korak nikako ne smete preskočiti, jer samo tako možete eliminisati sve mikroorganizme koji bi mogli uzrokovati probleme tokom čuvanja zimnice. Lepa&Srećna ukazuje da je ovaj postupak najvažniji jer pravilno sterilizovana staklenka značajno smanjuje rizik od pojave plesni.
- Nakon što se staklenka napuni džemom, važno je da je pravilno hermetički zatvorite. Ovaj korak je ključan jer pravilno zatvorena teglja stvara vakuum koji sprečava ulazak vazduha i mikroorganizama. Nakon što se džem ohladi, proverite da li je poklopac uvučen, jer ukoliko to nije slučaj, džem neće biti dobro zatvoren i trebalo bi da ga odmah potrošite ili držite u frižideru. Ako pri pritisku na poklopac čujete karakterističan „klik“, to znači da je tegla dobro zatvorena i da će džem imati duži rok trajanja. Prehrambeno-biotehnološki fakultet naglašava da je ovo takođe ključno za sprečavanje razvoja plesni, jer je u suprotnom težište za ulazak mikroorganizama otvoreno.
Kada je u pitanju skladištenje džema, i ovo je vrlo važan faktor. Neotvorene staklenke trebate čuvati na hladnom, tamnom i suvom mestu, kao što je smočnica. Izbegavajte da ih držite u blizini izvora toplote ili na mestima sa direktnim izlaganjem sunčevim zracima, jer to može oslabiti vakuumski pečat na poklopcu. Nakon što otvorite džem, obavezno ga čuvajte u frižideru kako biste produžili njegov rok trajanja i sprečili pojavu plesni. Blic ističe da ovi uslovi omogućavaju da džem zadrži svoj kvalitet i svežinu, a istovremeno sprečavaju kontaminaciju.
Iako buđ na džemu može delovati kao manji problem, ona predstavlja ozbiljnu pretnju zdravlju, zbog čega je ključno pravilno postupiti s takvim džemovima. Ove informacije su korisne kako bi se svi koji pripremaju domaće zimnice zaštitili od mogućih zdravstvenih komplikacija i sačuvali kvalitet svojih proizvoda za buduće upotrebe. Pobediti plesni i mikotoksine je moguće, ali samo uz odgovorno postupanje i pridržavanje osnovnih pravila sigurnosti i sterilizacije.
















